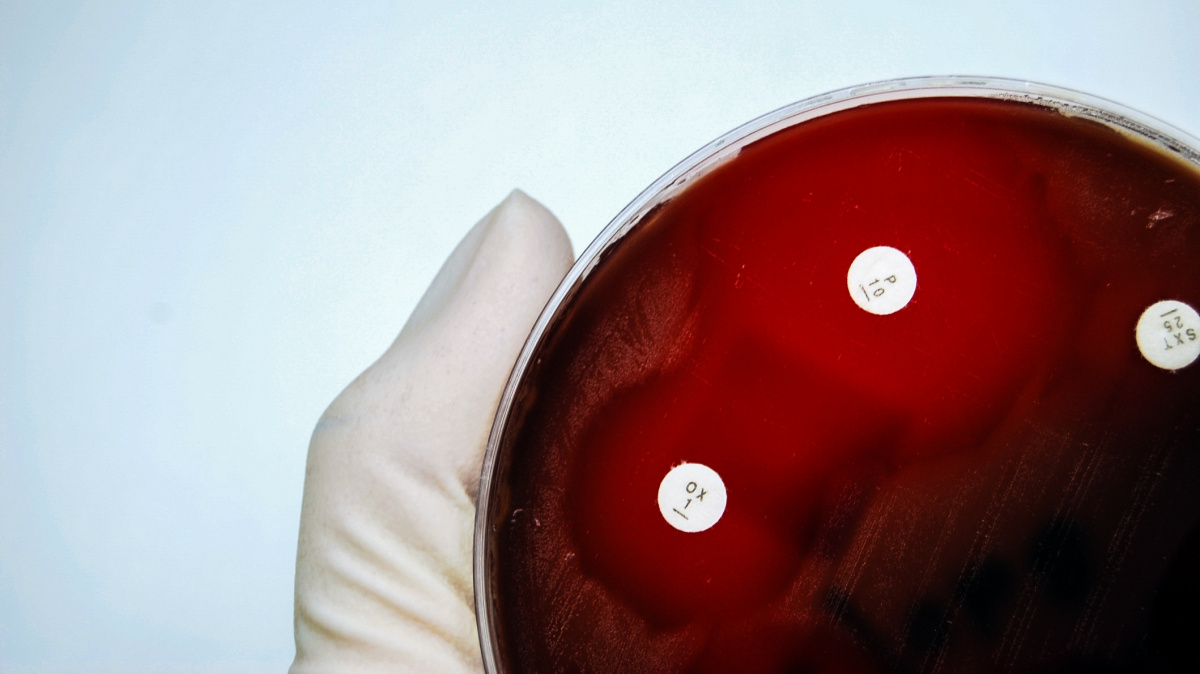
Přijde bakteriální apokalypsa? Pár 'zbraní' ještě máme, vývoj antibiotik ale vázne

Články s tagem: zdraví a životní styl
Člověk
Převratný objev českých vědců: Rh faktor ovlivňuje náchylnost k různým nemocem
10. 2. 2016
|
Jan Toman
Krev není voda. O tom, že je tato životodárná tekutina kolující našimi cévami opravdu unikátní, se mohl přesvědčit každý, kdo ji někdy daroval nebo přijímal krevní transfuzi. Ze záhadné, pro život nezbytné substance se přičiněním lékařů a biologů v průběhu 20. století vyklubala viskózní směs vody, nezbytných živin a krevních buněk – červených i bílých krvinek a krevních destiček.
Člověk
Transplantace zvířecích orgánů: Čeká nás revoluce ve zdravotnictví?
22. 1. 2016
|
Jan Toman
Co mají společného nejnovější techniky genové manipulace, pokrok ve zkoumání kmenových buněk a hádající se američtí medikové? Zadními vrátky se k nám připlížila budoucnost. A dává o sobě hlasitě vědět. Zcela představitelnými a s nynější technikou uskutečnitelnými se stávají biomedicínské postupy, které ještě před pár lety vévodily vědeckofantastickým románům. Pokud se nevynoří nějaká zásadní překážka, během několika let bude zřejmě možné lidem transplantovat speciálně upravené zvířecí orgány či orgány vypěstované ve zvířatech z lidských buněk. Příznivci těchto transplantací lákají na dlouhý a zdravý život, zatímco odpůrci straší scénami jak vystřiženými z filmu Ostrov doktora Moreaua. Zdravotnické instituce mezitím nabádají k opatrnosti, ale pokrok si hledá vlastní cesty…
Člověk
Jaká tajemství skrývají římské latríny?
16. 1. 2016
|
Jan Toman
Vědní obory se někdy potkávají na opravdu neobvyklých místech. Vezměme si třeba historickou parazitologii – výzkum toho, jakými cizopasníky trpěli naši předkové. Aby na tuto zajímavou otázku mohli odborníci najít odpověď, tak si musí zahrát na detektivy. Ve stylu Indiana Jonese cestují po muzeích a archeologických nalezištích a vyhledávají dobře zachované lidské pozůstatky. Jen jim, pravda, nejde o zlaté artefakty, ale cosi mnohem titěrnějšího – mikroskopické zbytky parazitických organismů. V tom ovšem potřebují pomoc archeologů, takže jejich bádání vyžaduje dobrou znalost biologie, lékařství i historických disciplín. Zachovaných těl je však poskrovnu, a tak se výzkumníci musí poohlédnout i jinde. Jedním z nejvydatnějších zdrojů informací se překvapivě ukázaly být lidské výměšky.
Člověk
Přijde bakteriální apokalypsa? Pár 'zbraní' ještě máme, vývoj antibiotik ale vázne
12. 1. 2016
|
Jan Toman
Zprávy o nebezpečí nadměrného předepisování antibiotik se v posledních letech staly takřka folklórem. Bakterie se této třídě léků pomalu ale jistě přizpůsobují a doby, kdy jedna pilulka penicilinu dokázala vyhubit všechny mikroby v nemocnici, jsou už dávno minulostí. Fenomén tzv. mikrobiální odolnosti neboli rezistence čím dál víc zasahuje i do našich každodenních životů. Z mnoha příkladů můžeme zmínit obtížně léčitelné kmeny tuberkulózy nebo kapavky, které v posledních letech nejsou výjimkou. V krajním případě se však lékaři stále mohou spolehnout na "antibiotika poslední záchrany". I nad nimi se už ovšem začínají stahovat temná mračna…
Magazín
Muži mají horší výdrž než ženy. Při sportu se rychleji unaví
9. 1. 2016
|
red
Ženy sice notoricky platí za slabší, něžnější pohlaví, ukazuje se však, že to má od pravdy daleko. Alespoň pokud jde o sport. Ženy lépe odolávají únavě, fyzické i psychické, jak zjistili francouzští vědci. Při sportu mají větší fyzickou odolnost.
Magazín
Léky v kořenkách: Bylinky, které vám můžou zachránit život (nebo aspoň peníze)
30. 12. 2015
|
Hana Dubnová
Používáte koření jen k ochucení jídla? Zkuste ho příště třeba při nachlazení nebo pro snížení cholesterolu. Není potřeba zobat na vše léky, o léčivých účincích koření věděli už staří Číňané. Babské rady mají i vědecká podložení.
Člověk
Vědci boří stereotypy. Ženský a mužský mozek se neliší
29. 12. 2015
|
roj
Proč se chování žen a mužů zdánlivě tolik odlišuje? Podle vědců je to jen zdání, protože ve skutečnosti nejsou mozky žen a mužů až tak odlišné, jak se dosud předpokládalo. A že má jedno pohlaví v průměru větší určitou oblast mozku? Je to jen průměr, překryvů je ve skutečnosti mnohem víc...
Magazín
Proč jsou zážitky mnohem lepším dárkem než hmotné statky
22. 12. 2015
|
Hana Dubnová
Co je lepší? Vyrazit do divadla, nebo dostat nový telefon? I když se může na první pohled zdát, že je lepší někomu dát hmotný dárek, vědci nesouhlasí. Hned několik studií naznačuje, že zážitky člověka naplňují větším štěstím. Dobrá zpráva pro nestíhající Ježíšky, ne?